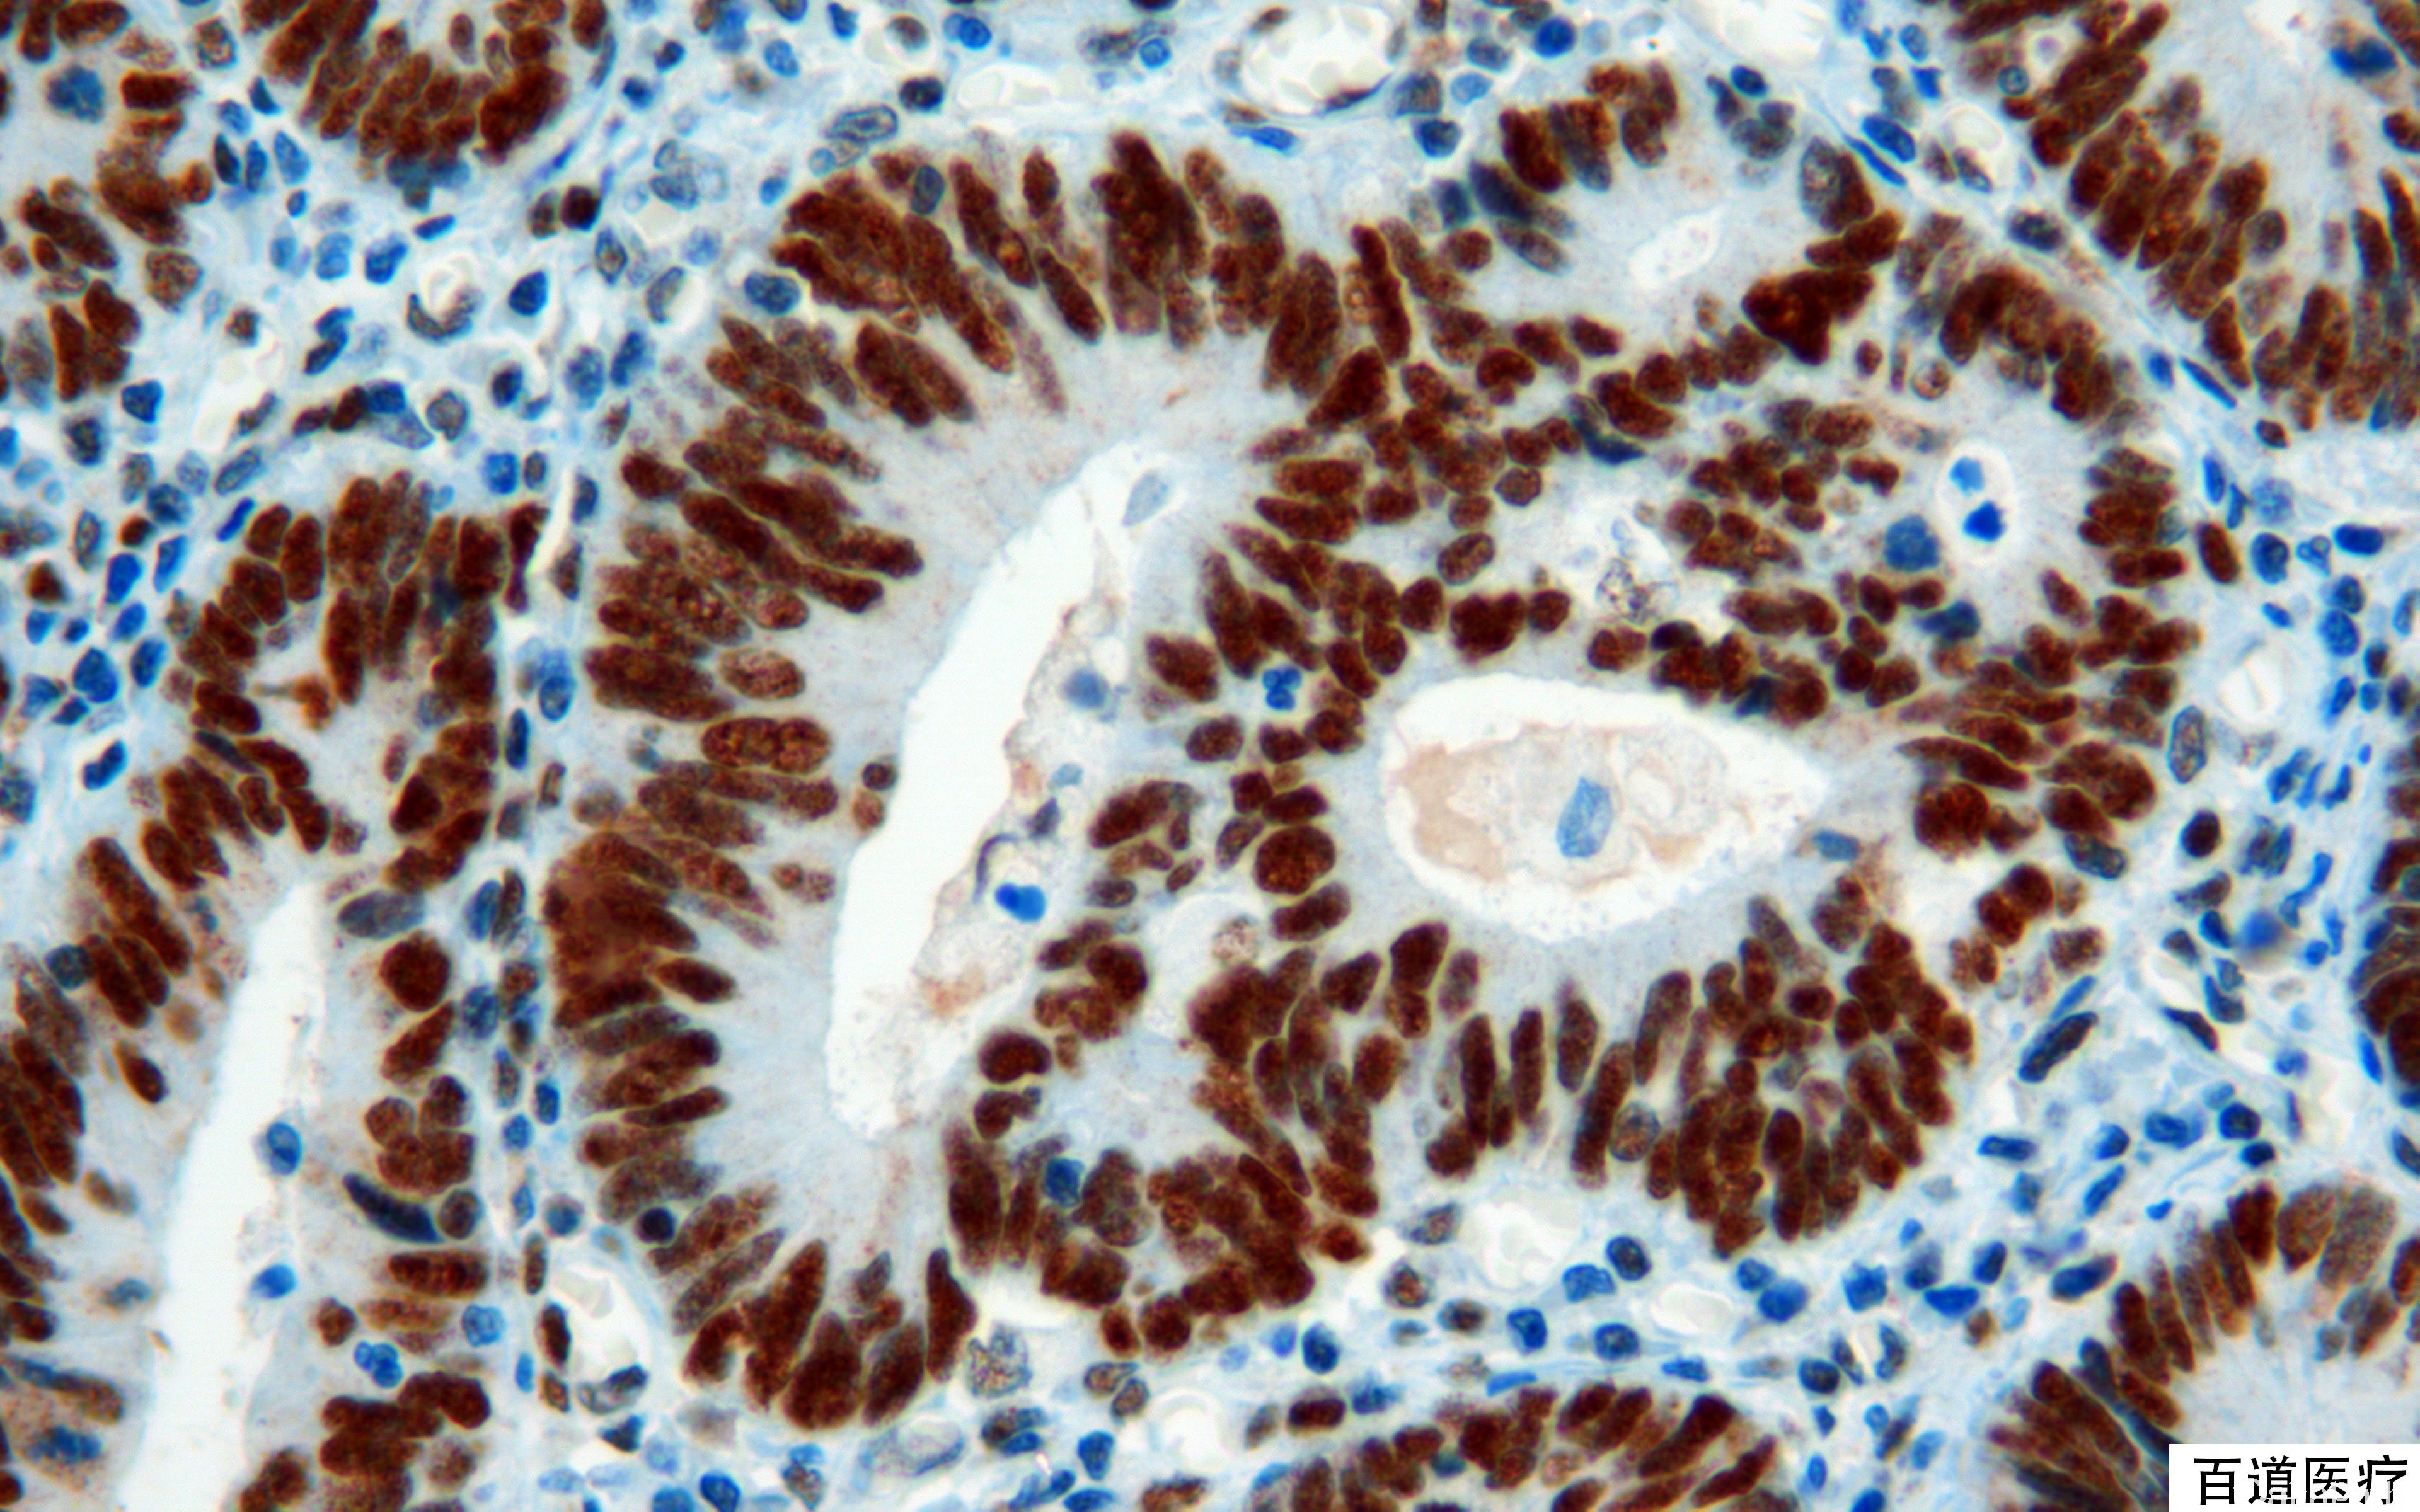

MSH2
别名: HMSH2;FE11;G219-1129
概述:
与 MLH1 相似,为 DNA 错配修复基因,正常结肠黏膜细胞核阳性,突变后表达丢失。hMSH2 与 hMSH6 组成的复合体主要识别单个碱基的错配突变和短缺失或插入突变;hMSH3 组成的复合体主要识别长片段的插入或缺失突变。
信号定位: 胞核
在病理学中的应用:
联合检测 MLH1, MSH2, PMS2 和 MSH6 可用于 Lynch syndrome(遗传性非息肉性结肠癌)的筛查。
MSH2 and disease* Lynch syndrome, hereditary non-polyposis colon cancer (HNPCC)
- Autosomal dominant _ Early age of onset _ Familial predisposition _ Colorectal carcinoma, gynecological and urological malignancies _ Molecular definition is based on germline mutation in one of the 4 major genes forming MMR system, 40% is caused by MSH2 _ Diagnosis by _ Amsterdam criteria (Gastroenterology 1999;116:1453) _ Bethesda Guidelines / US National Cancer Institute (J Natl Cancer Inst 1997;89:1758) _ Revised Bethesda Guidelines (J Natl Cancer Inst 2004;96:261) Jerusalem criteria, recommending that either MMR IHC or MSI testing be carried out on every colorectal tumor if the patient is <70 years at diagnosis (Gastroenterology 2010;138:2197)
- Muir-Torre syndrome
- Autosomal dominant
- Sebaceous neoplasms and visceral malignancies
- Mainly caused by MSH2 mutation
- MMR defect and sporadic colorectal cancer
- 10 and 15% of sporadic colon cancers; this MSI phenotype is associated with proximal primary tumor location, high grade, mucinous pathology, early stage, females, smoking and older age at onset
- Most are thought to arise from sessile serrated adenomas or polyps
- The majority are caused by MLH1 methylation and inactivation
商品化试剂(排名不分先后,本网站对抗体质量不负责!)
公司 | 克隆号 | 即用型(ml) | 原液(ml) | ||||
基因科技 | 25D12 | / | 2 | 4 | 7 | / | 0.2 |
赛诺特 | G219-1129 | 1 | 3 | 6 | / | 0.1 | 0.2 |
中杉金桥 | RED2 | 1.5 | 3 | 6 | / | 0.1 | 0.2 |
安必平 | G219-1129 | 1.5 | 3 | 6 | / | 0.1 | 0.2 |
福建迈新 | 25D12 | 1.5 | 3 | 6 | / | / | 0.2 |
在肿瘤中的表达情况:
几乎全部阳性(≥95%的病例阳性): 卵巢子宫内膜样癌、恶性黑色素瘤、鼻窦腺癌,肠型、壶腹腺癌,肠型、透明细胞肾细胞癌、梭形和上皮样细胞痣、皮脂腺上皮瘤、壶腹腺癌,胰胆管型、卵巢透明细胞癌、子宫内膜浆液性癌、壶腹腺瘤、十二指肠腺瘤,非壶腹部、胃腺癌、壶腹癌、锯齿状腺瘤、胰腺导管腺癌
通常阳性(<95%,≥75%的病例阳性): 结直肠腺癌、腺泡状软组织肉瘤、子宫癌肉瘤、子宫内膜透明细胞癌、子宫内膜腺癌、小肠腺癌、结直肠淋巴上皮瘤样癌、结直肠腺癌,家族息肉病相关
经常阳性(<75%,≥55%的病例阳性): 皮脂腺腺癌、恶性混合性苗勒管肿瘤,间质成分、恶性混合性苗勒管肿瘤,上皮成分
有时阳性(<55%,≥35%的病例阳性): 皮脂腺腺瘤
少数阳性(<35%,≥15%的病例阳性): 结直肠黏液性腺癌
几乎全部阴性(<5%的病例阳性): 食管未分化癌